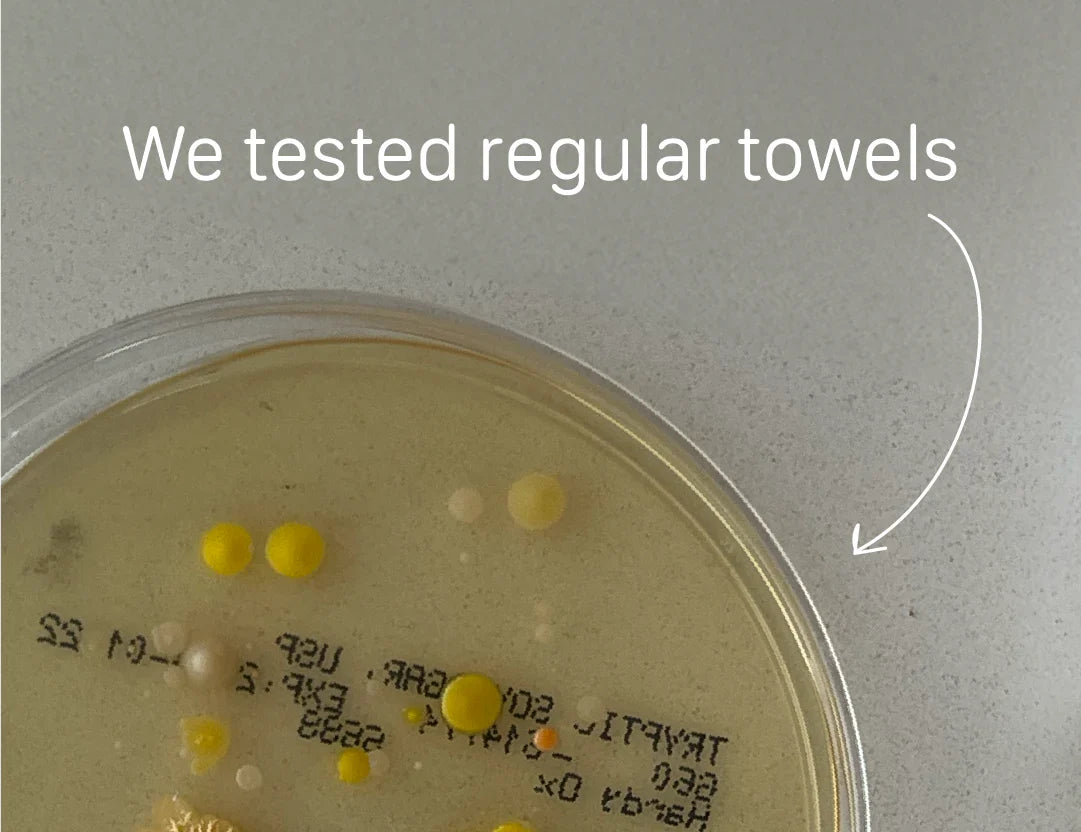
Bamteek’s Culture Test Reveals Shocking Results

What’s Really on Your Towel? Bamteek’s Culture Test Reveals Shocking Results
When it comes to skincare, the tools you use are just as important as the products themselves. Your towel, for example, is a key player in your daily routine—but how clean is it, really? At Bamteek, we decided to dig a little deeper and ran a culture test on regular towels to see what’s lurking beneath the surface. The results were eye-opening, to say the least.
The Experiment
We tested a clean regular towel to detect bacteria. Even though the towel was cleaned, our culture test revealed the presence of bacterial colonies—showing that "clean" towels might not be as clean as you think.

The Shocking Findings
Our culture test revealed specific bacterial colonies that thrive on towels:
-
Yellow colonies: These are likely Staphylococcus aureus, a common bacterium that can grow in such conditions. It is often found on human skin, towels, or surfaces.
-
White or pale colonies: These could be Staphylococcus epidermidis or other skin flora commonly found on towels and surfaces.
-
Orange dots: These colonies could represent a pigmented bacterium like Serratia marcescens, which can sometimes be found in moist environments.

Why It Matters
Every time you use a contaminated towel, you’re transferring bacteria, dust, and residue onto your skin. For those with sensitive skin or acne-prone areas, this could lead to irritation, clogged pores, or even infections. Your towel might be undoing all the hard work your skincare routine aims to achieve.
The Bamteek Difference
Our findings reaffirm why Bamteek’s biodegradable face towels are a game-changer for your skincare routine. Made from 100% eucalyptus plant viscose, our towels are single-use, ensuring a fresh, clean surface every time. Here’s how they stack up:
Why Make the Switch?
Your skin deserves better than a bacteria filled towel. Switching to Bamteek not only improves your skincare routine but also ensures peace of mind knowing you’re treating your skin with the care it deserves. Say goodbye to laundry residue, dust build-up, and harmful bacteria, and hello to healthier, happier skin.